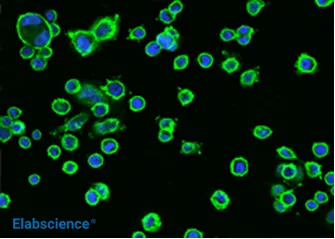

Rabbit Monoclonal Antibodies
Due to the distinctiveness of the rabbit immune system, rabbit monoclonal antibodies (mAbs) demonstrate superior antigen recognition capabilities compared to traditional mouse-derived monoclonal antibodies. Elabscience® leverages advanced second-generation rabbit monoclonal technology to develop high-quality antibodies, dedicated to fulfilling our clients' antibody product requirements.

Featured Cases
Ideal for IHC, IF, and IP, and for challenging antigens. Rigorously validated for reproducible science.

IHC on human kidney tissue using the ACE2 rabbit mAb (AN300027P)

IHC on human tonsil tissue using the Bcl-2 rabbit mAb (AN300032P)

IHC on human spleen tissue using the CD14 rabbit mAb (AN300175P)
Key Features
Next-gen antibodies: where rabbit meets recombinant precision.

Human-like Epitopes
Target conserved/conformational epitopes mouse mAbs often miss.

Ultra-low Cross-reactivity
Near-zero off-target binding in complex samples.

100% Lot Consistency
Sequence-verified clones. Identical performance, every batch. Guaranteed.

Ethically Engineered
Zero animal sacrifice post-B cell harvest. Fully in vitro production.

High-affinity & Lower Costs
Detect low-abundance targets with less antibody per test.

Superior Signal-to-Noise Ratio
Delivers clearer results by minimizing background and maximizing specificity.
The Rabbit mAb Edge: No More Tradeoffs
| Mouse mAb | Rabbit pAb | Rabbit mAb | |
|---|---|---|---|
| Specificity | Moderate (single epitope) | Low (cross-reactivity) | High (single epitope & conformational targeting ) |
| Batch Consistency | ★★★★ Variable (hybridoma drift) | ★★ Poor (response varies by animal) | ★★★★★ Excellent (recombinant) |
| Affinity Range | 10-8 – 10-9 M | 10-9 – 10-10 M | 10-11 – 10-12 M |
| Ethical Production | Low (ascites/mice) | Medium (bleeding) | High (cell-culture only) |
| Time to Result | Standard | Standard | Faster (optimized protocols) |

Figure 4. The specificity and affinity of rabbit monoclonal antibodies are higher than those of rabbit polyclonal antibodies and mouse monoclonal antibodies

Figure 5. Rabbit monoclonal primary antibody displays antibody affinity level in the picomolar range compare to typical MAbs

Figure 6. Rabbit antisera recognizes a wider range of epitopes than the mouse
Validation You Can Cite, Results You Can Replicate
Badge System
•MS/MS-verified Specificity
•Application-Specific Optimization (IHC-P, Flow, ELISA)
•Stability Testing: 24mo shelf-life at 4°C
•Animal-free Recombinant Production (ISO 9001)
Data Spotlight
•Lot-to-lot coefficient of variation (CV) <5% in ELISA (n=6 batches)